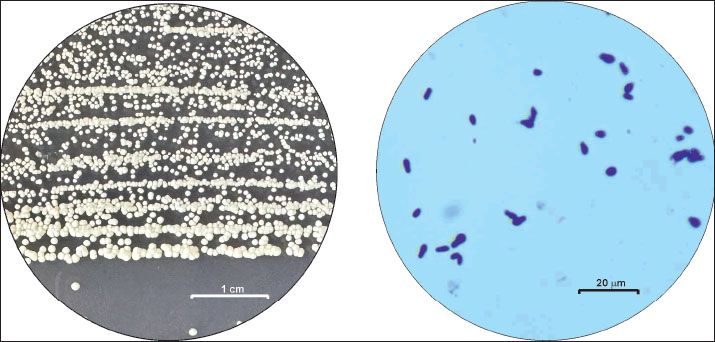

| Research Article | ||
Open Vet. J.. 2025; 15(9): 4354-4361 Open Veterinary Journal, (2025), Vol. 15(9): 4354-4361 Research Article Prevalence of Malassezia pachydermatis yeasts in clinical infections in dogs: A single-center retrospective study at the University Veterinary Hospital, Stara Zagora, Bulgaria (2019–2023)Velina Dinkova* and Nikolina RusenovaDepartment of Veterinary Microbiology, Department of Infectious and Parasitic Diseases, Faculty of Veterinary Medicine, Trakia University, Stara Zagora, Bulgaria *Corresponding Author: Velina Dinkova. Department of Veterinary Microbiology, Infectious and Parasitic Diseases, Faculty of Veterinary Medicine, Stara Zagora, Bulgaria. Email: velina.dinkova [at] yahoo.com Submitted: 22/04/2025 Revised: 20/07/2025 Accepted: 08/08/2025 Published: 30/09/2025 © 2025 Open Veterinary Journal
AbstractBackground: Malassezia yeasts are part of the resident microbiota of canine skin and ear canal. The compromised immunity of animals, changes in environmental factors, and antibacterial treatment often result in their proliferation and subsequent complications. Aim: This single-center retrospective study was designed to investigate the prevalence of Malassezia spp. yeasts as agents of mono- and co-infections in dogs with clinical signs of inflammation referred to the University Veterinary Hospital, Stara Zagora, in 2019–2023. Methods: Swab samples of ear, nasal, conjunctival, throat discharges, wound, abscess, and fistula discharges, and skin lesion fluid were collected from dogs with clinical inflammation using sterile cotton applicators, immediately transferred to Stuart transport medium, and inoculated on different culture media within 24 hours. The presence of microorganisms was reported based on isolation in pure culture or as the predominant isolate in a mixed culture. The yeasts were identified by the specific growth morphology of colonies and cell morphology. Data analysis included the year of isolation, sampling site, and microbial pathogen genus. The differences in the prevalence of yeasts according to the sampling site were assessed using the chi-square test and test of independent proportions. Results: During 2019–2023, the microbiological examination of 896 swab samples from dogs with clinical signs of inflammation referred to the University Veterinary Hospital, Stara Zagora, resulted in 201 unique Malassezia pachydermatis identifications, including 189 from otitis and 12 from skin lesions. The 5-year prevalence of yeasts in dogs with ear infections was 60.19% (95% confidence interval 51.92%–69.41%) and in dogs with skin infections was 4.11% (95% confidence interval 2.12%–7.18%). Malassezia pachydermatis was the only infectious agent in 32.3% of dogs with otitis. In 39.8% of cases, it was associated only with staphylococci, whereas polymicrobial infections were less frequently registered. In dogs with skin lesions, M. pachydermatis was always isolated together with a bacterial pathogen, most often staphylococci. Conclusion: The relatively constant presence of M. pachydermatis in canine clinical samples from otitis and skin infections implies that targeted testing for yeasts should not be omitted with regard to more accurate diagnosis of the etiological agents and successful treatment outcome. Keywords: Yeasts, Otitis, Skin lesions, Canine clinical samples. IntroductionMalassezia spp. are lipid-dependent yeasts belonging to the family Malasseziaceae, order Malasseziales within the phylum Basidiomycota (Laniri, 2022). Currently, 18 species have been identified based on molecular analyses and physiological peculiarities (Díaz et al., 2024). Malassesia spp. require lipid-supplemented culture media to improve the isolation (Cabañes, 2014), with the exception of the lipophilic Malassezia pachydermatis (M. pachydermatis) that grows well on Sabouraud Dextrose Agar (SDA) due to its ability to utilize lipid fractions from the SDA peptone component (Ilahi et al., 2017; Hobi et al., 2022). Malassezia yeasts were first isolated from the skin of humans, followed by other warm-blooded vertebrates, and later from a range of ecological niches, establishing them as one of the most widespread and adaptable fungal genera (Richards et al., 2012; Theelen et al., 2018; Hobi et al., 2022). Malassezia species are among the most common agents colonizing the oily areas of the skin and mucosal sites of healthy dogs and cats based on cultural characteristics or molecular methods (Brito et al., 2009; Bond et al., 2020; Hobi et al., 2022). Numerous studies have identified M. pachydermatis as the dominant species in the cutaneous mycobiota of dogs, whereas other species are also present in the cutaneous mycobiota of cats (Eidi et al., 2011; Bond et al., 2020; Guillot and Bond, 2020; Meason-Smith et al., 2020). Mycelial fungi and yeasts cause dermatomycosis in companion animals. Malassezia otitis and dermatitis are the most relevant superficial mycoses in dogs and cats. The most common fungal isolates from skin lesions are M. pachydermatis (29.14%), Candida spp. (27.07%), and dermatophytes (23.5%), while M. pachydermatis accounts for 80% of fungal otitis externa isolates (Dworecka-Kaszak et al., 2020; Daniel, 2022). The non-lipid-dependent species M. pachydermatis is frequently associated with canine ceruminous otitis externa and seborrheic dermatitis. The compromised immunity of animals, changes in environmental factors, and antibacterial treatment often result in yeast proliferation and subsequent complications. Folds, underlying hypersensitivity, and endocrinopathies favour skin disease. The diagnosis is based on the detection of yeast in ear and skin lesions by cytology and culture (Moraru et al., 2019; Guillot and Bond, 2020). The public health importance of Malassezia species increases due to their ability to colonize pets; therefore, their role as zoonotic pathogens should not be underestimated (Chupryna et al., 2024). In humans, these yeasts may be involved in skin diseases, such as atopic dermatitis, folliculitis, psoriasis, and Pityriasis versicolor. Malassezia spp. have increasingly been reported in severe systemic infections, especially among immunocompromised patients receiving parenteral nutrition and premature neonates (Rhimi et al., 2020; Abdillah and Ranque, 2021). A report of a neonatal fungemia outbreak caused by M. pachydermatis showed that the causative strain was isolated from dogs owned by health care workers in the involved nursery unit (Chang et al., 1998). In a later study (Morris et al., 2005), the carriage of M. pachydermatis in healthy and diseased dogs with allergic dermatitis or otitis externa was compared to that of healthy human owners, and M. pachydermatis DNA was identified on the palms of over 90% of pet owners, regardless of the disease state of their dogs. Based on culture results indicating the relative abundance of Malassezia species, owners of affected dogs were 11 times more likely to be culture-positive than owners of healthy dogs (Morris et al., 2005). All these facts and the lack of recent information about yeasts as canine pathogens in the country have motivated the present single-center retrospective study on the prevalence of Malassezia spp. yeasts as agents of mono- and co-infections in dogs with clinical signs of inflammation referred to the University Veterinary Hospital, Stara Zagora, in 2019–2023. Materials and MethodsSamplesThis retrospective study was conducted on samples from patients referred to the University Veterinary Hospital in Stara Zagora, Bulgaria, between 2019 and 2023. The inclusion criteria were the animal species (dogs only) and the presence of clinical inflammation necessitating microbiological examination to identify the underlying pathogen(s). A total of 896 swab samples of ear, nasal, conjunctival, throat discharges, wound, abscess and fistula discharges, and skin lesion fluid were collected from dogs with clinically manifested inflammation using sterile cotton applicators, immediately transferred to Stuart transport medium (Deltalab™, Spain), and processed within 24 hours. Among them, 165 swab samples were negative while 731 were culture-positive. Table 1 presents the swab distribution according to sampling site and the number of bacterial and yeast isolates for the study period. Table 1. Distribution of swab samples and microbial findings according to the origin of the sample.
Identification of the isolatesCollected samples were plated on blood agar with 5% defibrinated sheep blood, MacConkey agar as a selective and differential medium for Enterobacteriaceae, and Sabouraud agar with 4% dextrose and 0.05 g/l chloramphenicol for yeasts (HiMedia™, India). The samples were aerobically incubated for 18–24 hours at 37°С. If no visible bacterial or yeast growth was detected after the initial incubation, the plates were left for another 24 hours at 37°C. The presence of microorganisms was reported based on isolation in pure culture or as the predominant isolate in a mixed culture. Bacterial pathogens were identified following the clinical veterinary microbiology guidelines based on conventional microbiological tests specific to the suspected isolates (Markey et al., 2013). The diagnostic algorithm for gram-positive cocci included gram staining, coagulase, catalase, oxidase tests, and additional tests if necessary. Gram-positive Corynebacterium spp. are distinguished by the growth of white colonies that are easily detached from the blood agar surface and negative oxidase and catalase tests. Gram-negative isolates were subcultured on polytropic Kligler iron agar (KIA, HiMedia™, India) and on a medium indicating H2S production, motility, and indole (SIM medium, HiMedia™, India). Pseudomonas spp. are distinguished by negative KIA results and positive oxidase and catalase test results. The yeasts were identified according to the specific growth and cell morphology of the colonies. After 48 hours of incubation at 37°C on SDA plates, round, smooth, white to creamy, convex, small yeast colonies (0.2–0.5 mm) were observed. By the 72nd hour under the same conditions, colony size has attained ≈1 mm (Fig. 1). On blood agar plates, a very subtle growth of whitish colonies was observed in the absence of bacterial microbiota. Microscopically, large Gram (+) yeast cells (3.0–6.5 × 2.5 µm) with a characteristic oval shape with wider, rounded base, resembling a peanut or a show print, arranged either solely or in pairs/clusters, were observed (Fig. 1).
Fig. 1. Left: macroscopic appearance of round, smooth, white to creamy, convex M. pachydermatis colonies on SDA after 72 h of incubation (bar=1 сm); right: Gram-stained smear showing the specific peanut shape of the yeast pathogen (bar=20 μm). Statistical analysisThe reported variables included the year of isolation, sampling site, presence or absence of bacterial coinfection, and microbial pathogen genus. The differences in the prevalence of M. pachydermatis according to the sampling site were assessed using the chi-square test and test of independent proportions. The chi-square test for trend was used to evaluate year-wise changes during the study period. p-values < 0.05 were considered statistically significant (MedCalc v.15.8). Ethical approvalPatients were examined after signing a standard informed consent form by the owner containing a clause authorizing the use of signalment and/or clinical data gathered during the procedures by the hospital’s academic staff for research purposes. The Manager of the University Veterinary Hospital of Trakia University allowed access to patient data, with full anonymity of the owner’s name, address, and phone number. ResultsThe microbiological examination of swab samples resulted in 201 unique Malassezia pachydermatis identifications, 189 from otitis and 12 from skin lesions, based on the macroscopic and microscopic appearance of colonies and cells and the ability of isolates to grow on a medium without lipid supplementation. For the 5-year period of study, the prevalence of yeasts in dogs with ear infections varied between 50.0% (in 2020) and 67.3% (in 2021), with an overall isolation rate for 2019–2023 of 60.19% (95% confidence interval 51.92%–69.41%) (Fig. 2). Compared with the total number of swab samples from skin lesions, the involvement of M. pachydermatis was significantly lower than that from otitis samples (p < 0.001). For the study period, the overall isolation rate was 4.11% (95% confidence interval 2.12%–7.18%). The distribution of skin yeast isolates over the years was markedly uneven: 30.8% in 2020 versus the absence of yeast isolates in 2022.
Fig. 2. Left: Prevalence of M. pachydermatis isolates from 314 culture-positive ear swab samples over the study years; right: M. pachydermatis percentages for individual years in skin samples. Malassezia pachydermatis was the only infectious agent in 32.3% of dogs with otitis (Fig. 3). Associations with a single bacterial isolate predominated during the study period (44.3%), exceeding both yeast monoinfection (р=0.0177) and all other polymicrobial combinations (p < 0.001). In dogs with skin lesions, M. pachydermatis was always isolated together with bacterial pathogens, most often staphylococci. During the study period, no significant year-wise difference (p=0.820) was observed between the percentage of M. pachydermatis monoinfection and that of mixed infections.
Fig. 3. Left: Percentage of M. pachydermatis monoinfection and co-infection patterns for the 2019–2023; right: year-wise distribution of M. pachydermatis mono- and co-infections. Table 2 shows the specific combinations of M. pachydermatis with one or more different groups of bacterial isolates. For co-infections with a single bacterial pathogen, the combination with Staphylococcus spp. was the most frequent, accounting for 90% of all cases. There was no significant difference between the prevalence rates of the five established combinations of M. pachydermatis + two bacterial pathogens. In five patients, M. pachydermatis was encountered together with Pseudomonas spp. and Enterobacteriaceae. Staphylococci were present in the four other combinations. Table 2. Malassezia pachydermatis isolates from otitis and skin lesions (n=201) from 2019 to 2023 and their association with bacterial pathogens.
DiscussionIn Bulgaria, the prevalence of M. pachydermatis in dogs with otitis externa in earlier investigations demonstrated considerably lower rates of infection: 25% in 2007–2011 (Petrov et al., 2013), 17% in 2010–2014 (Terziev and Urumova, 2018), and 30% in 2013–2017 (Petrov et al., 2019). These data and our results demonstrate a steadily increasing presence of M. pachydermatis and support the necessity of detecting their overgrowth and including antifungal treatment to avoid the emergence of yeast dermatitis or otitis. The etiology of otitis in dogs and cats is multifactorial and complex, involving bacterial and fungal pathogens. However, a recent study in Serbian veterinary clinics reported M. pachydermatis as the only isolated yeast pathogen in 68% of tested canine otitis swabs (Tesin et al., 2023). In Iran, Malassezia spp. were detected in 72.73% of dogs with skin/ear disease history in 2022–2023 (Mikaeel et al., 2025). At a Brazilian veterinary school hospital, from 523 culture-positive samples from dogs with clinical otitis external growth of yeasts was found in 5.7% (30/523) and mixed infections in another 30 samples. M. pachydermatis was isolated in the majority of those samples (54/523) (Ferraz et al., 2021). In 237 dogs with otitis externa in Stavropol (Russian Federation), Malassezia spр. were isolated as the only agent in 19.4% of samples and together with bacteria in 44.3% of samples (Deneva et al., 2020). Co-infections of bacteria and Malassezia spp. were found in 10.2% of 138 dogs (Martins et al., 2022), with the rate of co-infections with Staphylococcus spp., Corynebacterium spp., and Bacillus spp. being 7%, 1%, and 1%, respectively. Similar to our results, staphylococci were also involved in the detected yeast polymicrobial infections. A survey from Poland analyzed 255 pyoderma and 219 otitis cases in dogs. Of pyoderma skin lesions, staphylococci were the only cause in 82.4% of patients, whereas co-infections with Malassezia spp. were less frequent (15.7%) than in our survey. For external ear infections, the prevalence of staphylococci in inflammation was lower (44.8%) than that of Malassezia spp. (58%) (Szewczuk et al., 2020). A study carried out from September 2019 to August 2020 at the Teaching Veterinary Clinical Complex, Nagpur Veterinary College, India, with 10,204 dogs presented for various problems, identified 255 dogs (2.5%) with Malassezia dermatitis (Dhoot et al., 2021), a rate comparable to the average prevalence in our study. Identifying and characterizing the cutaneous microbiota reveal how microbial diversity may contribute to cutaneous diseases and the roles of different microorganisms in the pathogenesis of dermatological illnesses. Considering the increasing evidence of the impact of the microbiota on mammalian health, the relationships between bacterial and fungal elements of the microbiota can be important. Tang et al. (2020) demonstrated an overall loss of microbial diversity and overgrowth of certain microbiota members in clinically affected dogs. Compared with healthy samples, 69.8%, 16.3%, and 7.0% of the clinically affected ear samples had bacterial, fungal, and both bacterial and fungal overgrowth, respectively. In this study, the most important microbial species that were enriched in clinically affected ears were M. pachydermatis, Staphylococcus pseudintermedius, and Staphylococcus schleiferi. The effect of antibiotic treatment on the number of cutaneous Malassezia yeasts is an important clinical aspect. A study in dogs demonstrated that Malassezia spp. overgrowth in dogs previously treated with antibiotics was significantly higher (p=0.015) than that in dogs not subjected to antimicrobial therapy (Berlanda et al., 2022). In contrast, Bloom (2022) affirmed that unlike Candida dermatitis, Malassezia dermatitis was not associated with a recent antibiotic application. The most recent data in dogs with bacterial otitis treated topically with antibiotics support the hypothesis that the populations of M. pachydermatis and Candida spp. may increase opportunistically in canine ears after efficient broad-spectrum antibacterial monotherapy, presuming that such otitis patients should be observed for yeast overgrowth (Juhola et al., 2025). A probable explanation is that changes in the ear microbiota after antibiotic treatment promote the overgrowth of yeasts through a change in the pH of the ear canal (Alshahni et al., 2021), while Nuttall (2016) observed that the buffering capacity of the ear skin was preserved. Our data confirm the results of studies where M. pachydermatis and S. pseudintermedius are often found together in dogs with pyoderma (Bajwa, 2017; Hobi et al., 2024), which was attributed to a symbiotic relationship between these organisms where staphylococci produce beneficial growth factors and change the environment to favor yeast growth. Another possible explanation is the existence of some common predisposing factors that can favor both the secondary bacterial infections and the overgrowth of this yeast pathogen. Several limitations of the study should be mentioned. One is the lack of molecular identification of yeast pathogens. However, in clinical practice, it may not be strictly necessary for the attending veterinarian to know the exact Malassezia species causing the disease, given that species variation in drug susceptibility is limited (Tragiannidis et al., 2010). The microbiological tests were limited to aerobic microorganisms, as anaerobes are not commonly recognized as pathogens on oxygen-exposed skin surfaces and in canine ear infections (Tang et al., 2020). The sensitivity of M. pachydermatis isolates to antimycotic drugs was not determined due to a lack of officially approved standard interpretation guidelines, the limited number of antimycotic preparations for topical use available on the national market, and the desire to keep examination and treatment costs to a reasonable level so that the owner does not refuse the microbiological examination. ConclusionThe relatively constant presence and recent trend for increased prevalence rates of M. pachydermatis in canine clinical swab samples from otitis and skin infections imply that targeted testing for yeasts should not be omitted with regard to more accurate diagnosis of the etiological agents and successful treatment outcome. Veterinary practitioners are advised to order a mycological examination in all cases of canine recurrent or chronic otitis/dermatitis for timely identification of yeast overgrowth. The ability of M. pachydermatis to adapt to new hosts and its potential for zoonotic transmission to dog owners should be continuously monitored from the One Health perspective. Further developments in both diagnostic and antifungal drug susceptibility testing must address these aspects. AcknowledgmentsThis study is part of Project 8 VMF/2023, “Classical and modern approaches for identification of microbial species in canine clinical samples with emphasis on coagulase-positive staphylococci.” Many thanks to all colleagues from the University Veterinary Hospital at the Faculty of Veterinary Medicine, Stara Zagora, and Daniela Ivanova for the statistical analysis of data. Conflict of interestThe authors declare no conflicts of interest. FundingThis study received no funding. Authors’ contributionStudy design: VD and NR; data collection: VD; data analysis: VD and NR; manuscript writing and editing: VD and NR; supervision: NR. Data availabilityThe data in this study are available from the corresponding author upon reasonable request. ReferencesAbdillah, A. and Ranque, S. 2021. Chronic diseases associated with Malassezia yeast. J. Fungi 7, 855. Alshahni, M.M., Alshahni, R.Z., Fujisaki, R., Tamura, T., Shimizu, Y., Yamanishi, C. and Makimura, K. 2021. A case of topical ofloxacin-induced otomycosis and literature review. Mycopathologia 186, 871–876. Bajwa, J. 2017. Canine Malassezia dermatitis. Can. Vet. J. 58, 1119–1121. Berlanda, M., Valente, C., Guglielmini, C., Danesi, P., Contiero, B. and Poser, H. 2022. Malassezia overgrowth in dogs in northern Italy: frequency, body distribution, clinical signs and effects of pharmacologic treatments. Vet. Ital. 58, 103–109. Bloom, P. 2022. The latest in diagnosis and management of Malassezia dermatitis. dvm360 53, 360,. Available via Bond, R., Morris, D.O., Guillot, J., Bensignor, E.J., Robson, D., Mason, K.V., Kano, R. and Hill, P.B. 2020. Biology, diagnosis and treatment of Malassezia dermatitis in dogs and cats clinical consensus guidelines of the world association for veterinary dermatology. Vet. Dermatol. 31, 28–74. Brito, E.H., Fontenelle, R.O., Brilhante, R.S., Cordeiro, R.A., Monteiro, A.J., Sidrim, J.J. and Rocha, M.F. 2009. The anatomical distribution and antimicrobial susceptibility of yeast species isolated from healthy dogs. Vet. J. 182, 320–326. Cabañes, F.J. 2014. Malassezia yeasts: how many species infect humans and animals?. PLoS Pathogens 10, e1003892. Chang, H.J., Miller, H.L., Watkins, N., Arduino, M.J., Ashford, D.A., Midgley, G., Aguero, S.M., Pinto-Powell, R., Von Reyn, C.F., Edwards, W., Mcneil, M.M., Jarvis, W.R. and Pruitt, R. 1998. An epidemic of Malassezia pachydermatis an intensive care nursery associated with colonization of health care workers’ pet dogs. New England J. Med. 338, 706–711. Chupryna, M.I., Ivanchenko, I.M., Severyn, R.V., Basko, S.O. and Dadyshko, A.O. 2024. Characteristics of the cause, epidemiological features, clinical signs, diagnosis and therapy of malassesiosis in dogs (review article). One Health J. 2, 5–12. Daniel, A.K. 2022. Canine malasseziosis: an overview. Indian J. Anim. Health 61, 228–234. Deneva, M., Orobets, V., Ozherredova, N., Svetlakova, E. and Grudeva, E. 2020. Analysis of the species composition of microorganisms in dogs with otomycosis. In E3S Web Conf, Rostov-on-Don, Russian Federation: EDP Sciences 2020175, p 03007. Díaz, L., Castellá, G., Bragulat, M.R. and Cabañes, F.J. 2024. Malassezia yeasts in animals in the next-generation sequencing era. In Human and animal relationships (The Mycota, 6). Eds., Brakhage, A.A., andKniemeyer, O. and Zipfel, P.F. Cham, Switzerland: Springer, 6. Dworecka-Kaszak, B., Biegańska, M.J. and Dąbrowska, I. 2020. Occurrence of various pathogenic and opportunistic fungi in skin diseases of domestic animals: a retrospective study. BMC Vet. Res. 16, 248. Eidi, S., Khosravi, A.R. and Jamshidi, S. 2011. A comparison of different kinds of Malassezia species in healthy dogs and dogs with otitis externa and skin lesions. Turkish J. Vet. & Anim. Sci. 35, 345–350. Ferraz, C.M., Morais, J., Loureiro, B., Rodrigues, J.A., Vilela, V.L.R., da Costa-Val Bicalho, A.P., dos Santos Horta, R., Langoni, H., Braga, F.R., Tobias, F.L. 2021. Microbial etiology and in vitro bacterial resistance profile in external dogs otitis: retrospective study in animals attended in the routine of veterinary hospital (2013 to 2020). Vet. Zootec. 28, 578. Guillot, J. and Bond, R. 2020. Malassezia yeasts in veterinary dermatology: an updated overview. Front. Cell. Infect. Microbiol. 10, 79. Hobi, S., Bęczkowski, P.M., Mueller, R., Tse, M. and Barrs, V.R. 2024. Malassezia dermatitis in dogs and cats. Vet. J. 304, 106084. Hobi, S., Cafarchia, C., Romano, V. and Barrs, V.R. 2022. Malassezia: zoonotic implications, parallels, and differences in colonization and disease in humans and animals. J. Fungi 8, 708. Ilahi, A., Hadrich, I., Neji, S., Trabelsi, H., Makni, F. and Ayadi, A. 2017. Real-time PCR identification of six Malassezia species. Curr. Microbiol. 74, 671–677. Juhola, J., Brennan, E., Ferguson, E.A., Loeffler, A., Hendricks, A., Frosini, S.M., Chang, Y.M. and Bond, R. 2025. Fungal dysbiosis following antibacterial monotherapy in canine otitis externa. J. Small Anim. Pract. 66, 149–157. Dhoot, K.D., Panchbhai, G.R.B., Chaudhari, S.V.U. and Kolangath, S. 2021. Prevalence of Malassezia infection in dogs of Nagpur City. Int. J. Cur. Microbiol. Appl. Sci. 10, 2269–2273. Laniri, G. 2022. S1.3a gGenetics andgenomics of Malassezia species. Med. Mycology 60, myac072. Markey, B., Leonard, F., Archambault, M., Cullinane, A. and Maguire, D. 2013. Clinical veterinary microbiology, 2nd ed. Edinburgh, UK, Elsevier. Martins, E., Maboni, G., Battisti R, da Costa, L., Selva, H.L., Levitzki, E.D. and Gressler, L.T. 2022. High rates of multidrug resistance in bacteria associated with small animal otitis: a study of cumulative microbiological culture and antimicrobial susceptibility. Microb. Pathog. 165, 105399. Meason-Smith, C., Olivry, T., Lawhon, S.D. and Hoffmann, A.R. 2020. Malassezia species dysbiosis in natural and allergen-induced atopic dermatitis in dogs. Med. Mycology 58, 756–765. Mikaeel, A., A., Karouei, S.M.H. and Pordeli, H.R. 2025. Prevalence of Malassezia spp. in the external ear canals of dogs from Gorgan, Iran and analysis of some predisposing factors. Bulgarian J. Vet. Med. 28, 293–300. Moraru, R., Chermette, R. and Guillot, J. 2019. Superficial mycoses in dogs and cats. In Recent trends in human and animal mycology. Eds., Singh, K. and Srivastava, N. Singapore, Singapore: Springer. Morris, D.O., O’Shea, K., Shofer, F.S. and Rankin, S. 2005. Malassezia pachydermatis carriage in dog owners. Emerg. Infect. Dis. 11(11), 83–88. Nuttall, T. 2016. Successful management of otitis externa. In Practice 38, 17–21. Petrov, V., Mihaylov, G., Tsachev, I., Zhelev, G. and Marutsov, P. 2013. Otitis externa in dogs: microbiology and antimicrobial susceptibility. Revue Méd. Vét. 164, 18–22. Petrov, V., Zhelev, G., Marutsov, P., Koev, K., Georgieva, S., Toneva, I. and Urumova, V. 2019. Microbiological and antibacterial resistance profile in canine otitis externa – a comparative analysis. Bulgarian J. Vet. Med. 22, 447–456. Rhimi, W., Theelen, B., Boekhout, T., Otranto, D. and Cafarchia, C. 2020. Malassezia spp. yeasts of emerging concern in fungemia. Front. Cell. Infect. Microbiol. 10, 370. Richards, T.A., Jones, M.D., Leonard, G. and Bass, D. 2012. Marine fungi: their ecology and molecular diversity. Ann. Rev. Mar. Sci. 4, 495–522. Szewczuk, M., Zych, S. and Sablik, P. 2020. Participation and drug resistance of coagulase-positive staphylococci isolated from cases of pyoderma and otitis externa in dogs. Slovenian Vet. Res. 57, 33–43. Tang, S., Prem, A., Tjokrosurjo, J., Sary, M., Van Bel, M.A., Rodrigues-Hoffmann, A., Kavanagh, M., Wu, G., Van Eden, M.E. and Krumbeck, J.A. 2020. The canine skin and ear microbiome: a comprehensive survey of pathogens implicated in canine skin and ear infections using a novel next-generation-sequencing-based assay. Vet. Microbiol. 247, 108764. Terziev, G. and Urumova, V. 2018. Retrospective study on the etiology and clinical signs of canine otitis. Comparative Clin. Pathol. 27(7), 7–12. Tesin, N., Stojanovic, D., Stancic, I., Kladar, N., Ružić, Z., Spasojevic, J., Tomanic, D. and Kovacevic, Z. 2023. Prevalence of the microbiological causes of canine otitis externa and the antibiotic susceptibility of the isolated bacterial strains. Pol. J. Vet. Sci. 26, 449–459. Theelen, B., Cafarchia, C., Gaitanis, G., Bassukas, I.D., Boekhout, T. and Dawson, T.L. 2018. Malassezia ecology, pathophysiology, and treatment. Med. Mycology 56, S10–S25. Tragiannidis, A., Groll, A., Velegraki, A. and Boekhout, T. 2010. Malassezia fungemia, antifungal susceptibility testing and epidemiology of nosocomial infections. In Malassezia and the skin. Science and clinical practice. Eds., Boekhout, T., Mayser, P., Guého-Kellermann, E. and Velegraki, A.Heidelberg, Germany: Springer, pp: 229–251. | ||
| How to Cite this Article |
| Pubmed Style Dinkova V, Rusenova N. Prevalence of Malassezia pachydermatis yeasts in clinical infections in dogs: A single-center retrospective study at the University Veterinary Hospital, Stara Zagora, Bulgaria (2019–2023). Open Vet. J.. 2025; 15(9): 4354-4361. doi:10.5455/OVJ.2025.v15.i9.42 Web Style Dinkova V, Rusenova N. Prevalence of Malassezia pachydermatis yeasts in clinical infections in dogs: A single-center retrospective study at the University Veterinary Hospital, Stara Zagora, Bulgaria (2019–2023). https://www.openveterinaryjournal.com/?mno=253827 [Access: January 25, 2026]. doi:10.5455/OVJ.2025.v15.i9.42 AMA (American Medical Association) Style Dinkova V, Rusenova N. Prevalence of Malassezia pachydermatis yeasts in clinical infections in dogs: A single-center retrospective study at the University Veterinary Hospital, Stara Zagora, Bulgaria (2019–2023). Open Vet. J.. 2025; 15(9): 4354-4361. doi:10.5455/OVJ.2025.v15.i9.42 Vancouver/ICMJE Style Dinkova V, Rusenova N. Prevalence of Malassezia pachydermatis yeasts in clinical infections in dogs: A single-center retrospective study at the University Veterinary Hospital, Stara Zagora, Bulgaria (2019–2023). Open Vet. J.. (2025), [cited January 25, 2026]; 15(9): 4354-4361. doi:10.5455/OVJ.2025.v15.i9.42 Harvard Style Dinkova, V. & Rusenova, . N. (2025) Prevalence of Malassezia pachydermatis yeasts in clinical infections in dogs: A single-center retrospective study at the University Veterinary Hospital, Stara Zagora, Bulgaria (2019–2023). Open Vet. J., 15 (9), 4354-4361. doi:10.5455/OVJ.2025.v15.i9.42 Turabian Style Dinkova, Velina, and Nikolina Rusenova. 2025. Prevalence of Malassezia pachydermatis yeasts in clinical infections in dogs: A single-center retrospective study at the University Veterinary Hospital, Stara Zagora, Bulgaria (2019–2023). Open Veterinary Journal, 15 (9), 4354-4361. doi:10.5455/OVJ.2025.v15.i9.42 Chicago Style Dinkova, Velina, and Nikolina Rusenova. "Prevalence of Malassezia pachydermatis yeasts in clinical infections in dogs: A single-center retrospective study at the University Veterinary Hospital, Stara Zagora, Bulgaria (2019–2023)." Open Veterinary Journal 15 (2025), 4354-4361. doi:10.5455/OVJ.2025.v15.i9.42 MLA (The Modern Language Association) Style Dinkova, Velina, and Nikolina Rusenova. "Prevalence of Malassezia pachydermatis yeasts in clinical infections in dogs: A single-center retrospective study at the University Veterinary Hospital, Stara Zagora, Bulgaria (2019–2023)." Open Veterinary Journal 15.9 (2025), 4354-4361. Print. doi:10.5455/OVJ.2025.v15.i9.42 APA (American Psychological Association) Style Dinkova, V. & Rusenova, . N. (2025) Prevalence of Malassezia pachydermatis yeasts in clinical infections in dogs: A single-center retrospective study at the University Veterinary Hospital, Stara Zagora, Bulgaria (2019–2023). Open Veterinary Journal, 15 (9), 4354-4361. doi:10.5455/OVJ.2025.v15.i9.42 |